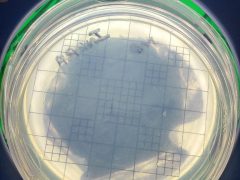

7530 Rainham Valley Ln, Richmond, Texas 77407, Nigeria
3422 Allen Parkway, Houston, Texas 77007, United States
1105 Williams Road, East Bernard, Texas 77435, United States
210 Verde Lake Way, Rosenberg, Texas 77469, United States
3802 Singing Coast Path, Houston, Texas 77082, United States
11329 Highcrest Drive, Conroe, Texas 77303, United States
38 Almeda Road, Houston, Texas 77004, United States
24 Lakeside Drive, Channelview, Texas 77530, United States
229 Ilfrey Street, Baytown, Texas 77520, United States